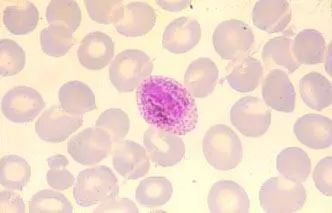

|
疟原虫本身就是病原体,真的能用来治疗癌症吗?科普中国微平台 2019-02-12 |
本文专家:郭晓强,博士、生命科学领域科普作家
2018年诺贝尔生理学或医学奖授予癌症免疫治疗以来,各种“奇思妙想”的报道接踵而来,令人目不暇接。最近,关于疟原虫可以治疗癌症的新闻,纷纷登上了各大媒体的头条。

一时间,引起了很多人的关注。对此很多人也表示质疑,这个曾经让人类害怕的“大魔头”,真的成了对战癌症的“特效药”?这种疗法真的可行吗?今天,我们就详细的和大家聊一聊。
为什么说疟原虫可以治疗癌症?
众所周知,疟原虫是导致疟疾的病原体,其治疗癌症无非具有两种可能。
第一种是直接效应。疟原虫可选择性杀死癌细胞,或直接吞噬或释放针对癌细胞的有毒物质,但这种神奇效应的可能性微乎其微。
(图片来源网络)
第二种是间接效应。疟原虫的感染激发机体免疫系统来抵抗,顺便把癌细胞也杀死了。这种“城门失火殃及池鱼”的策略倒是屡见不鲜。早在十九世纪末,借助细菌感染杀死肿瘤细胞实际上就是这一策略的体现。
用疟原虫治疗癌症可行吗?
首先是潜在致病性。如果用活疟原虫(无论是野生还是去除治病因子),它们都仍具有很大的致病性,尽管目前有治疗疟疾的药物,但是也不敢保证百分百有效。
其次是风险难控性。即使疟原虫不引发严重疾病,但疟原虫含太多物质,具有“大杂烩”的味道,很难避免其中的成分引发严重临床副反应的可能,给患者带来不必要的痛苦。
第三是效率低的问题。由于疟原虫是一种生物体,在体内的运输效率和扩散效应都远远低于小分子药物(如顺铂、紫杉醇和格列卫),也低于大分子抗体药物(如赫赛汀和贝伐单抗等),这也严重限制了治疗效率。
总体而言,如果疟原虫引发疟疾治疗癌症是通过间接激活免疫系统实现的,那么这一策略的前景很难说乐观。这里以疫苗发展为例,传统疫苗是采用减毒或失活的病原体,而现在则利用基因工程制备的关键蛋白甚至蛋白片段,大大简化了制备流程并增加了安全性。同样道理,目前可以采用较为安全的免疫激活策略来实现肿瘤治疗目的(像去年诺贝尔奖的免疫负调控因子抑制剂),自然减少了用病原体来激活免疫系统这种风险性较高、效率较低方案。从这个角度来讲,采用诱导疟疾而实现肿瘤治疗的策略很难称得上是一种理想方案。

但作为一种经验性大于理论性的肿瘤治疗,也很难判断疟原虫治疗癌症百无一用,作为一种选择到可以尝试。也许对某种特殊类型的肿瘤确实具有一定疗效。

(图片来源网络)
综合判断,疟原虫治疗肿瘤目前只能是一种尝试,目前很难说得上成功,更谈不上达到“治愈”效果。癌症仍是一种顽疾,面前治疗效果距离公众预期仍有很大差距,自然引发寻找新的治疗策略,疟原虫治疗肿瘤最终走向成功还是失败则需要进一步的发展来证明。
责任编辑:王超
科普中国APP
科普中国微信
科普中国微博

最新文章
-
为何太阳系所有行星都在同一平面上旋转?
新浪科技 2021-09-29
-
我国学者揭示早期宇宙星际间重元素起源之谜
中国科学报 2021-09-29
-
比“胖五”更能扛!我国新一代载人运载火箭要来了
科技日报 2021-09-29
-
5G演进已开始,6G研究正进行
光明日报 2021-09-28
-
“早期暗能量”或让宇宙年轻10亿岁
科技日报 2021-09-28
-
5G、大数据、人工智能,看看现代交通的创新元素
新华网 2021-09-28








